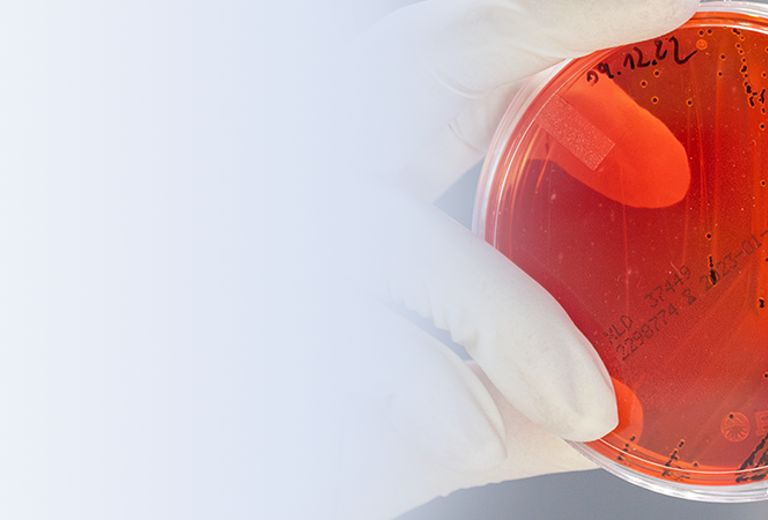
Eine Hand mit einem weißen Handschuh hält eine Petrischale mit rotem Agar.

Unsere kulturelle Infektionsdiagnostik ist ein verlässlicher Partner für Ihre kalkulierte antimikrobielle Chemotherapie. Die exakte Erregerdiagnostik (teilweise durch MALDI-ToF-MS) ist auf aktuellem taxonomischen Stand und ermöglicht eine epidemiologische Kommentierung mit vielen hilfreichen Hinweisen für Diagnostik und Therapie. Die Resistenztestungsbatterien sind auf die jeweiligen pharmakodynamischen und pharmakokinetischen Bedürfnisse z. B. in Urin, Stuhl, Abstrich bzw. für die lokale oder systemische Therapie, auch im tiefen Kompartiment, zugeschnitten. Die Testung erfolgt mit dem standardisierten Mikrodilutionsverfahren. Eine fundierte mykologische Diagnostik - Dermatophyten, Hefen, Schimmelpilze - erleichtert Ihr diagnostisches und therapeutisches Procedere.
Wir führen ein großes Spektrum umwelt- und krankenhaushygienischer Untersuchungen einschließlich Wasseruntersuchungen durch und beraten Sie in Fragen der Krankenhaus- und Praxishygiene.
Für spezielle diagnostische, therapeutische, epidemiologische umwelt- und krankenhaushygienische Fragestellungen stehen wir Ihnen gerne zur Verfügung.
Prä - und Postanalytik
der Mikrobiologie
Geben Sie hier den Begriff ein, den Sie in unserem Analysenverzeichnis suchen möchten
Ansprechpartner
bei analytisch-technischen Fragestellungen:
Kiana Mohajeri
Fachmikrobiologin in der med. Mikrobiologie
> E-Mail schreiben
Ansprechpartner
in medizinischen Fragestellungen:
Dr. med. Daniela Jacobsen
— Fachärztin für Mikrobiologie, Virologie und Infektionsepidemiologie, Dipl. für Tropenmedizin —
Tel.: +49 (0)421/2072-105
> E-Mail schreiben